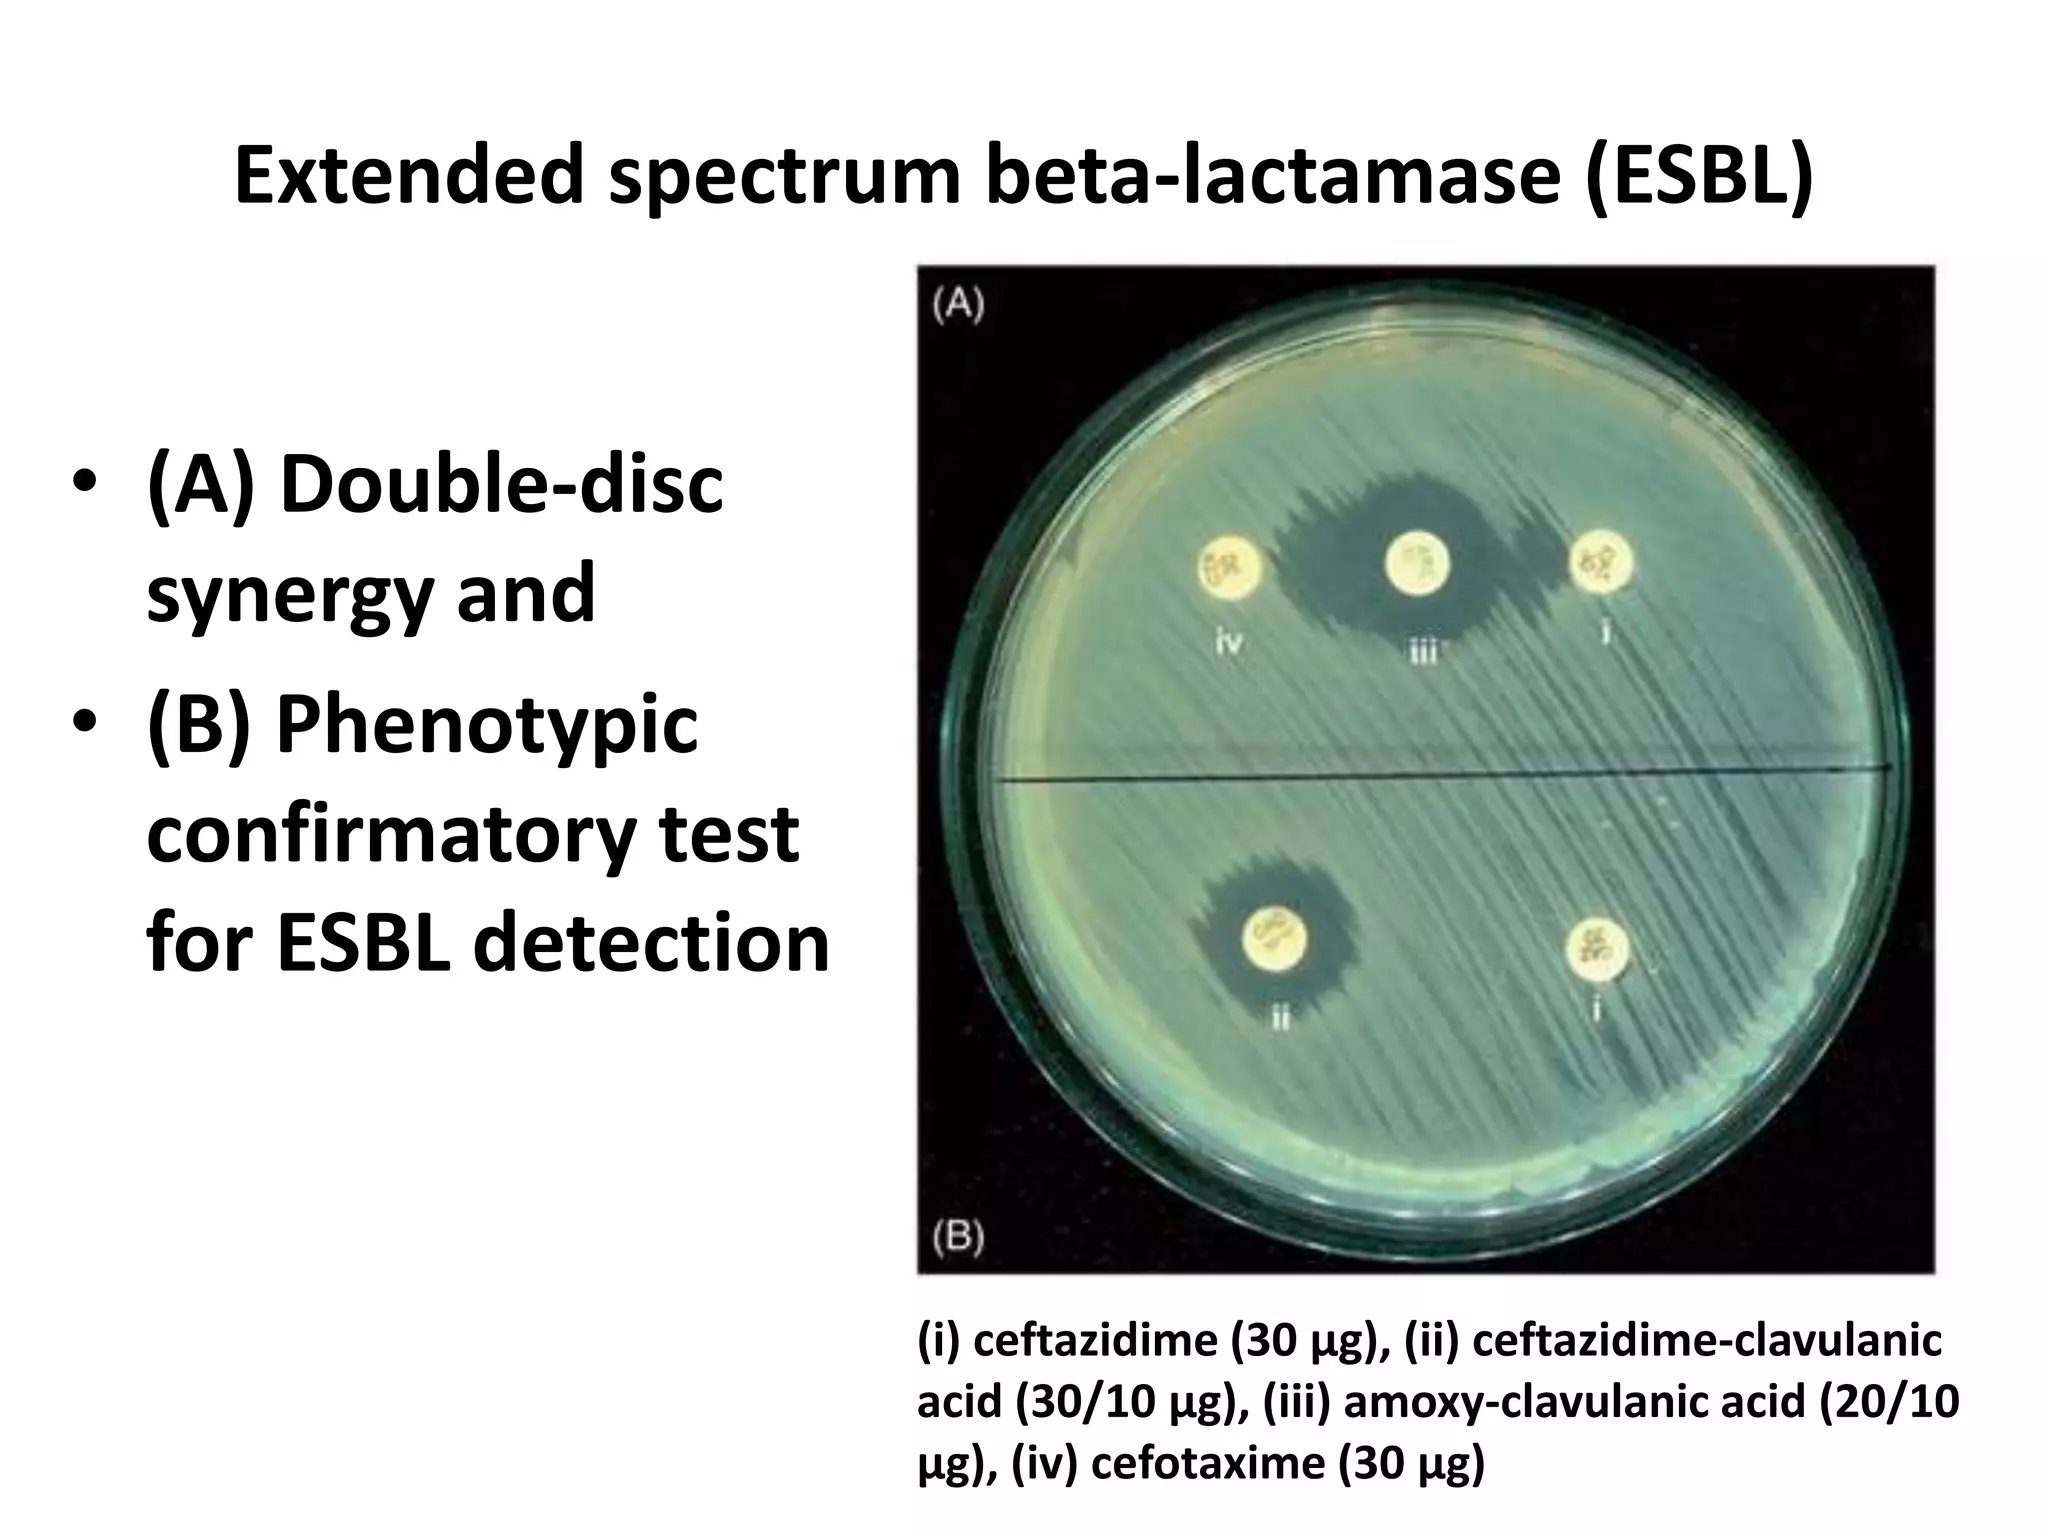
• (A) Double-disc
synergy and
• (B) Phenotypic
confirmatory test
for ESBL detection
Extended spectrum beta-lactamase (ESBL)
(i) ceftazidime (30 μg), (ii) ceftazidime-clavulanic
acid (30/10 μg), (iii) amoxy-clavulanic acid (20/10
μg), (iv) cefotaxime (30 μg)
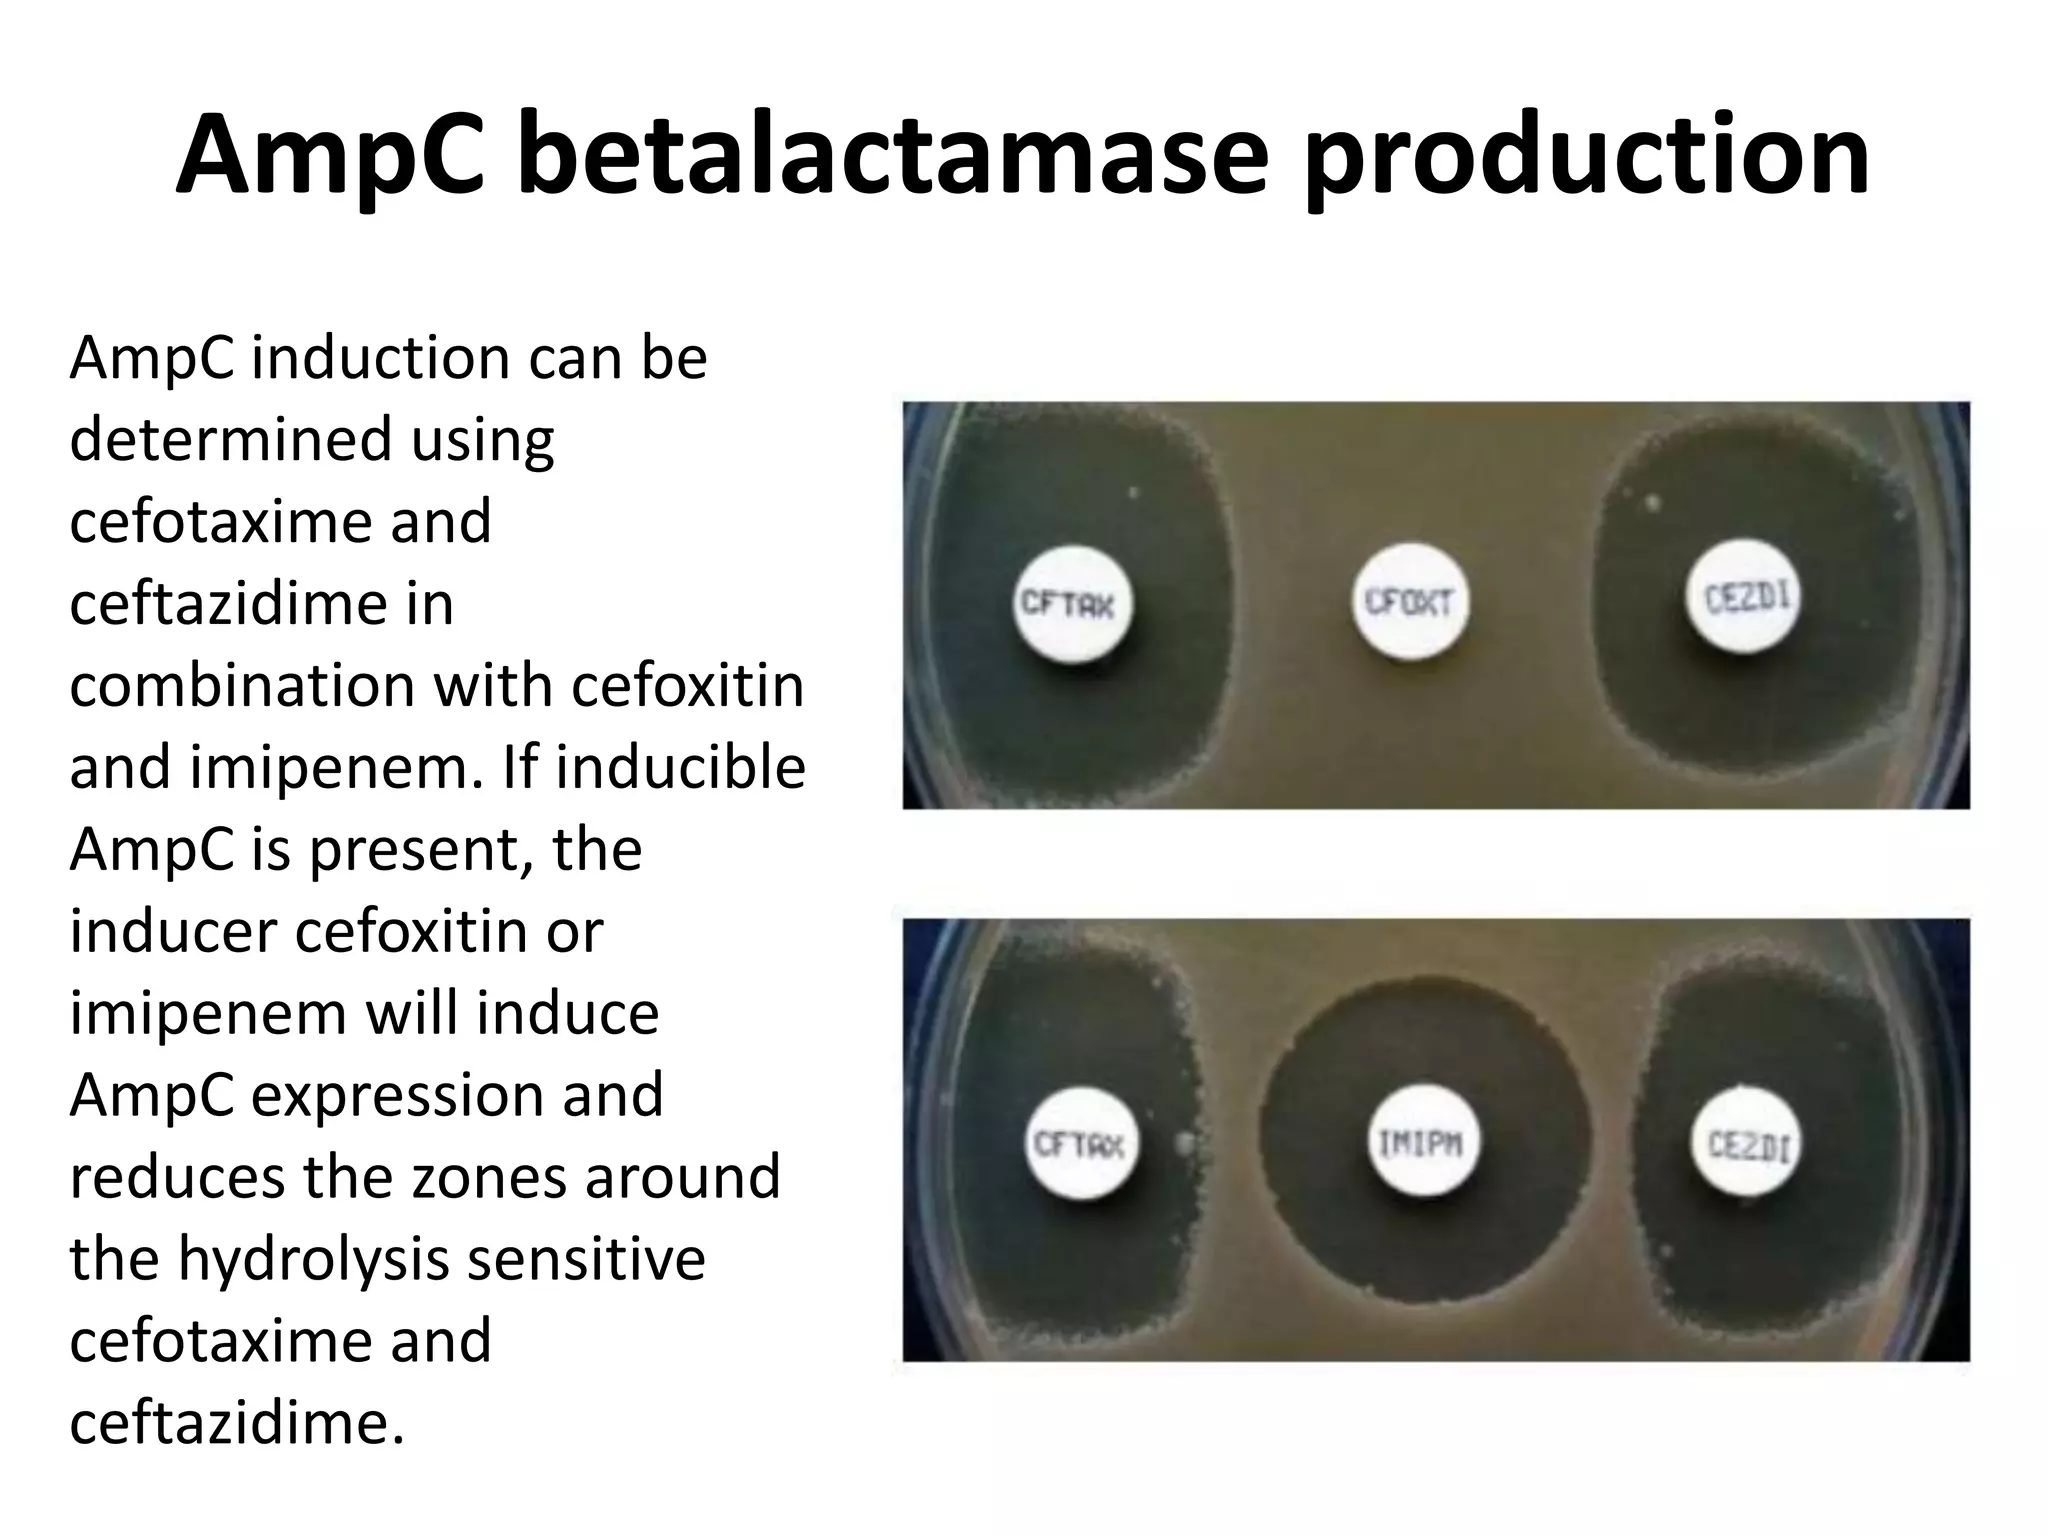
AmpC betalactamase production
AmpC induction can be
determined using
cefotaxime and
ceftazidime in
combination with cefoxitin
and imipenem. If inducible
AmpC is present, the
inducer cefoxitin or
imipenem will induce
AmpC expression and
reduces the zones around
the hydrolysis sensitive
cefotaxime and
ceftazidime.
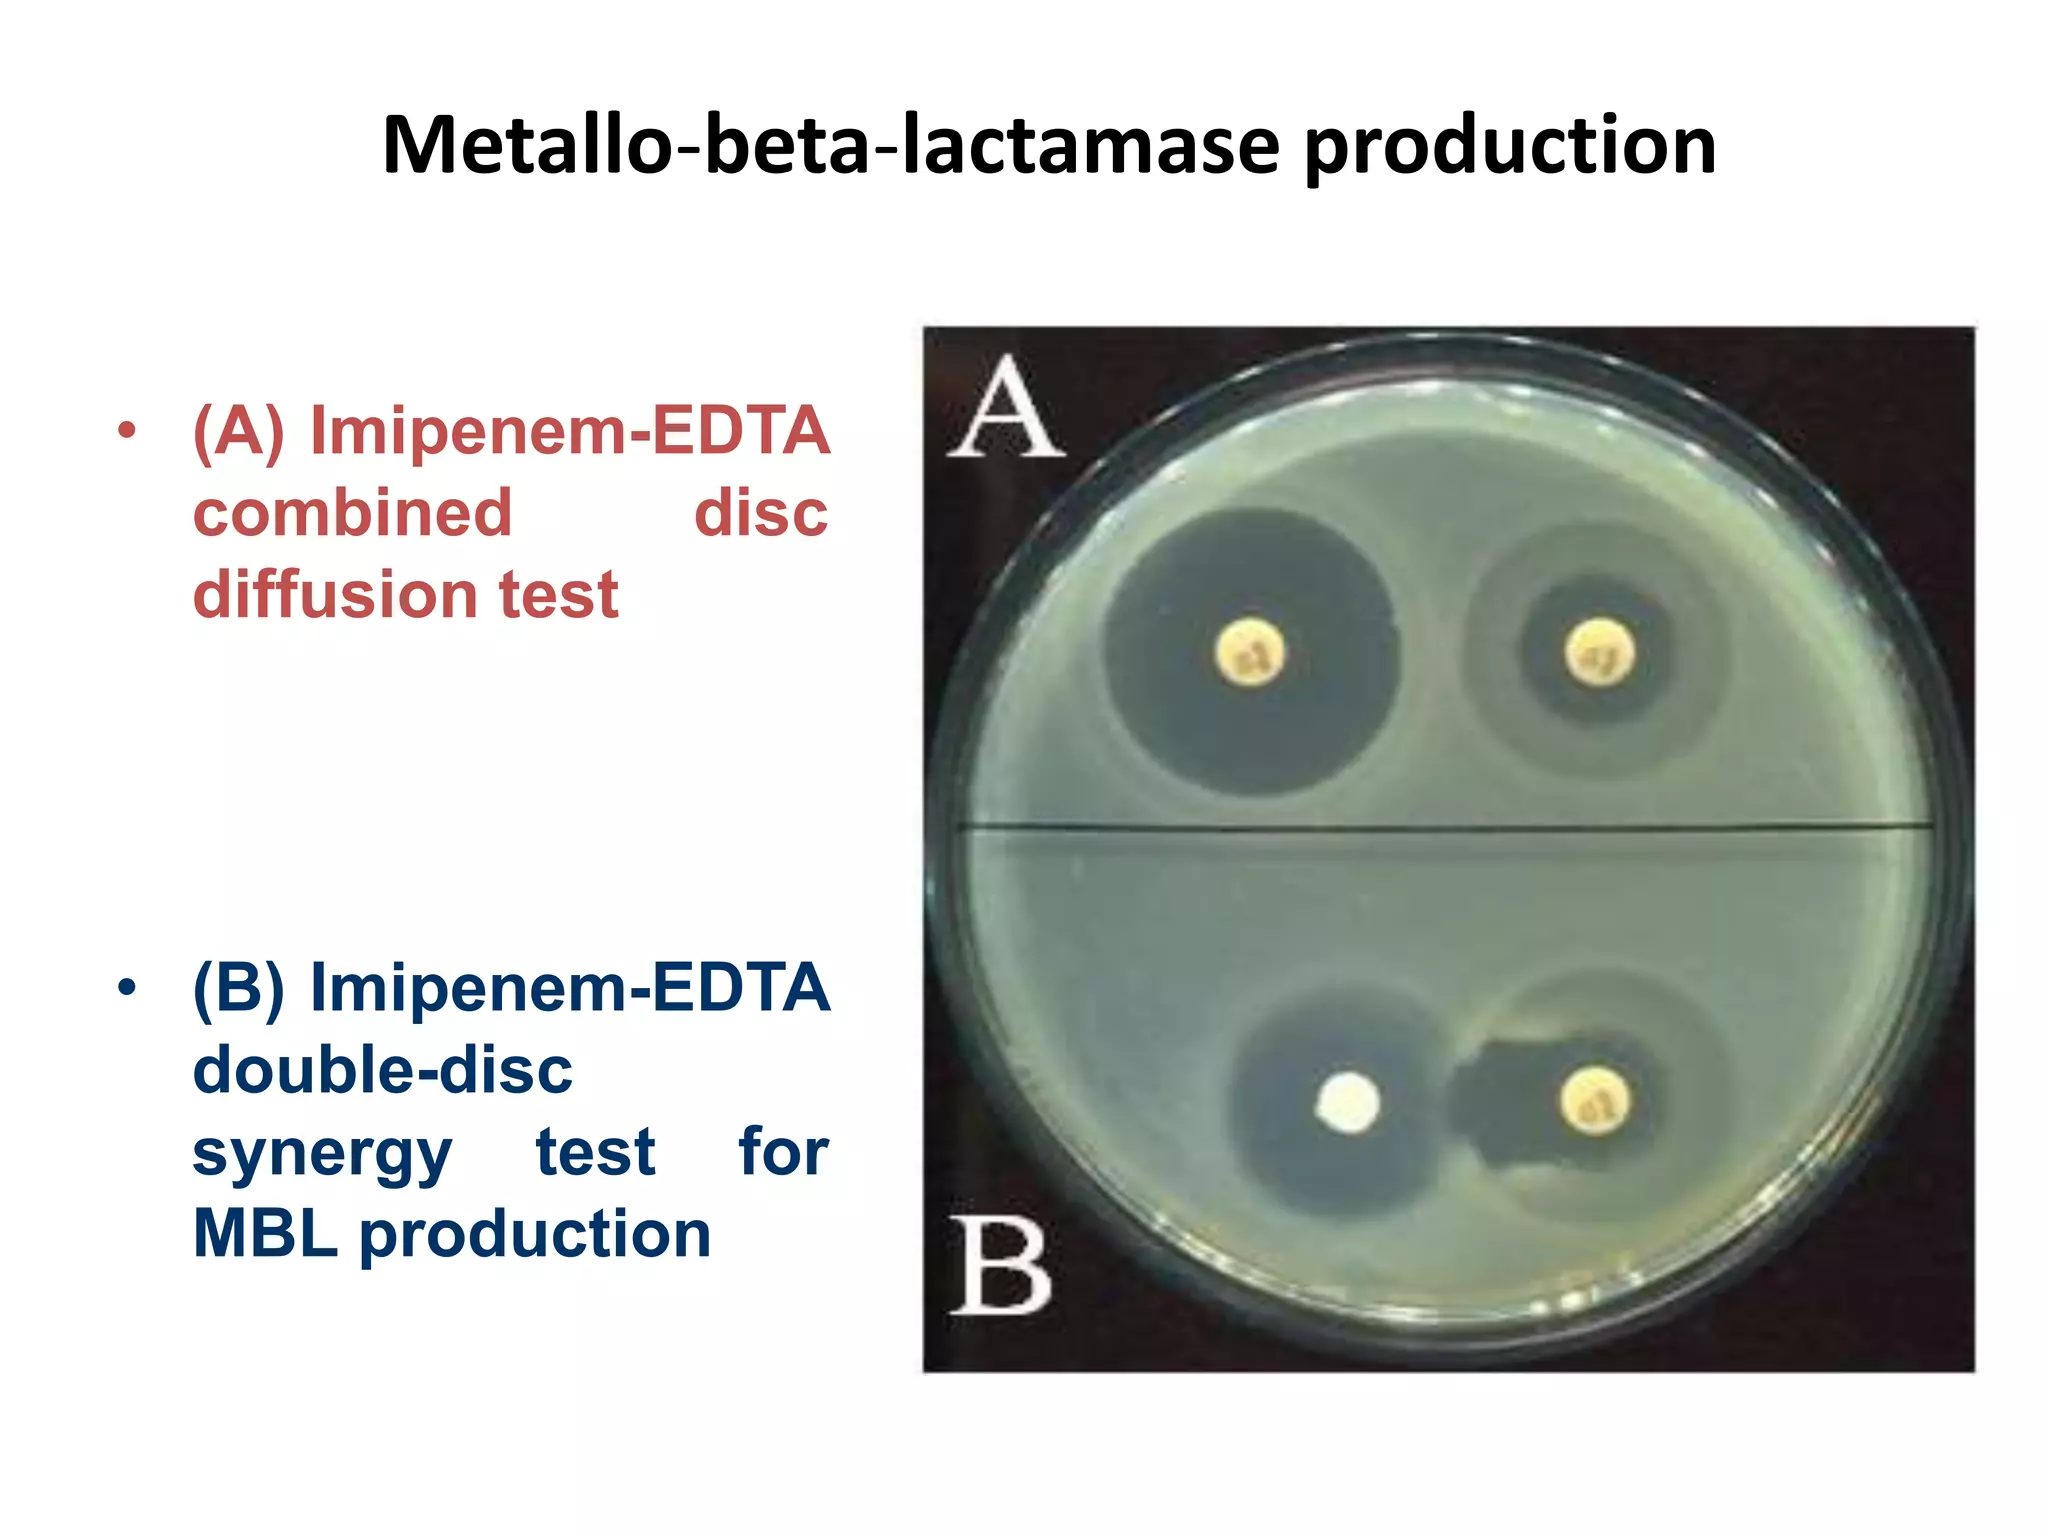
Metallo-beta-lactamase production
• (A) Imipenem-EDTA
combined disc
diffusion test
• (B) Imipenem-EDTA
double-disc
synergy test for
MBL production

Antimicrobial Susceptibility Testing involves procedures like diffusion and dilution methods to determine the susceptibility of microorganisms to antimicrobial agents. Key procedures discussed include Kirby-Bauer, agar and broth dilution tests. Interpretation of results defines organisms as susceptible, intermediate or resistant based on breakpoints. Quality control through reference strains is important to ensure accuracy and consistency of results. Automated methods now provide rapid and reproducible susceptibility testing through microdilution and detection of growth in broth cultures.








![Disc Diffusion For Fastidious Organisms
• Streptococcus pneumoniae / Streptococcus pyogenes
– MHA supplimented with 5% sheep blood
• Haemophilus spp.
– Haemophilus Test medium [MHA supplemented with
factor V (NAD) and Factor X (hematin)]
– 35C in an atmosphere of 5% CO2 for 16 - 18 hrs
• Neisseria gonorrhoeae
– Thayer-Martin agar [MHA supplemented with 5%
chocolate sheep blood and antibiotics (VCN inhibitor)]
– 35C in an atmosphere of 5% CO2 for 20 - 24 hrs](https://image.slidesharecdn.com/antimicrobialsusceptibilitytesting-210723065215/75/Antimicrobial-susceptibility-testing-9-2048.jpg)